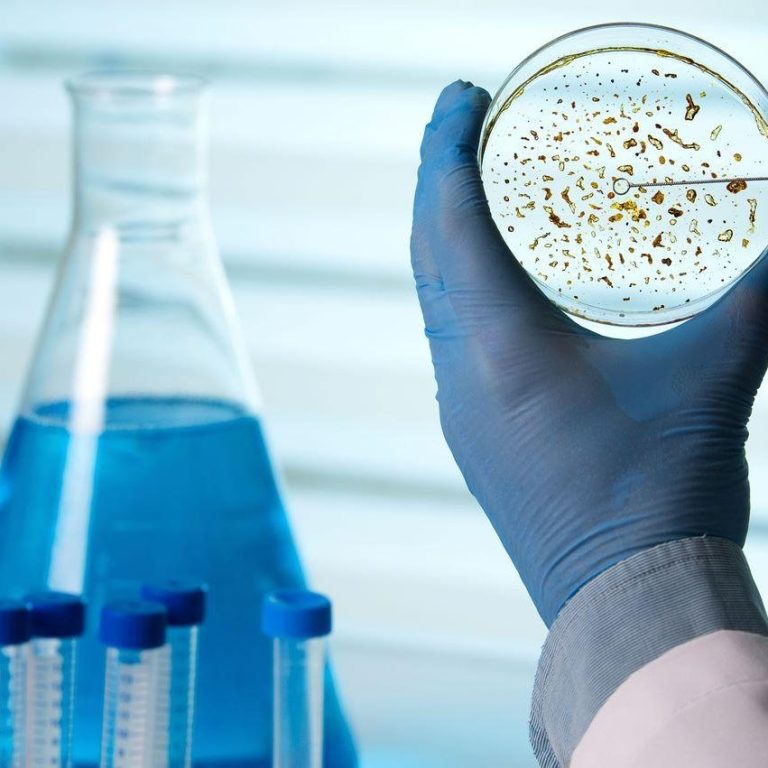

Regenerative Medicine
Regenerative therapies offer the potential to greatly enhance the healing process and improve
patients’ quality of life, helping them lead more active and
fulfilling lives—even when
facing ongoing health conditions.

What is regenerative medicine?
Regenerative medicine is an innovative area of medical science focused on restoring or rebuilding human tissues and bone to help reestablish normal function. At the Regenerative Medicine, our mission is to support the body’s natural ability to heal and renew itself.
Today’s advanced technologies, therapeutic products, and treatment protocols make it possible to accelerate healing, improve recovery times, and enhance long-term health. Our cells are constantly exposed to stress from environmental toxins, poor nutrition, lack of activity, medications, and other lifestyle factors. When cellular function declines, we begin to feel fatigued, look aged, and become more vulnerable to illness.
That’s why we take a cellular level approach to wellness addressing the root of dysfunction to help you feel and function at your best
Types Of Regenerative Medicine
Explore our key offerings and advancements in regenerative healing:
Innovative therapies, and groundbreaking research.
Stem Cell Treatments
Stem cell therapy is a form of regenerative medicine that uses unique, adaptable cells to help repair damaged tissues. This treatment is commonly used for conditions like back pain, particularly to support the regeneration of spinal disc tissue. Stem cells are remarkable in that they begin without a defined role in the body, but have the ability to transform into specialized cells needed for healing and repair.
Exosome Therapy
Exosome therapy is an advanced regenerative treatment that utilizes tiny, cell-derived particles known as exosomes. These microscopic vesicles are naturally released by cells and are packed with powerful bioactive compounds—including proteins, lipids, and RNA. When introduced into the body, exosomes help facilitate healing, reduce inflammation, and support the regeneration of damaged tissues by communicating with surrounding cells.
Platelet-Rich Plasma (PRP)
Platelet-rich plasma (PRP) therapy is founded on the idea that the natural healing properties within your own blood—specifically platelets and plasma—can aid in tissue repair and recovery. Commonly used in sports medicine, PRP is often applied to treat tendon injuries and support musculoskeletal healing. The process involves drawing a small amount of the patient’s blood, which is then spun in a centrifuge to concentrate the platelets and plasma, resulting in a solution that is significantly richer in healing components than normal blood.
Contact us
Telephone: 305-791-4599
E-mail: info@theregenerativemedicinelab.com
1002 NE 125th St North Miami, FL 33161
If you're exploring advanced regenerative solutions for your practice, we welcome the opportunity to share our latest data, clinical insights, and therapeutic applications. Our team is actively engaged in ongoing research and physician collaboration, with a strong focus on real-world outcomes and patient-centered innovation.
Whether you're evaluating new treatment options or looking to stay ahead in the evolving field of biologics, we're here as a resource. Simply complete the short form, and a clinical advisor will follow up to provide the information most relevant to your interests.